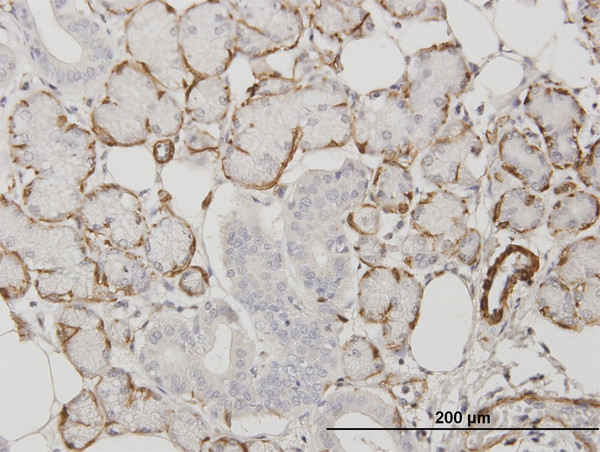
ACTA2 Antibody in Immunohistochemistry (Paraffin) (IHC (P))

Search
Abnova
ACTA2 Monoclonal Antibody (1D11-2B9)
{{$productOrderCtrl.translations['antibody.pdp.commerceCard.promotion.promotions']}}
{{$productOrderCtrl.translations['antibody.pdp.commerceCard.promotion.viewpromo']}}
{{$productOrderCtrl.translations['antibody.pdp.commerceCard.promotion.promocode']}}: {{promo.promoCode}} {{promo.promoTitle}} {{promo.promoDescription}}. {{$productOrderCtrl.translations['antibody.pdp.commerceCard.promotion.learnmore']}}


Please note: We are reviewing Western blot images included in the antibody testing data in our catalog, including those provided by third parties. Unless expressly labeled or annotated as “raw-unedited”, Western blot images included in the antibody testing data in our catalog may have been edited, optimized or otherwise adjusted for presentation.
产品信息
H00000059-M01
种属反应
宿主/亚型
分类
类型
克隆号
抗原
偶联物
形式
浓度
规格
纯化类型
保存液
内含物
保存条件
运输条件
产品详细信息
Sequence of this protein is as follows: MCEEEDSTAL VCDNGSGLCK AGFAGDDAPR AVFPSIVGRP RHQGVMVGMG QKDSYVGDEA QSKRGILTLK YPIEHGIITN WDDMEKIWHH SFYNELRVAP EEHPTLLTEA PLNPKANREK MTQIMFETFN VPAMYVAIQA VLSLYASGRT TGIVLDSGDG VTHNVPIYEG YALPHAIMRL DLAGRDLTDY LMKILTERGY SFVTTAEREI VRDIKEKLCY VALDFENEMA TAASSSSLEK SYELPDGQVI TIGNERFRCP ETLFQPSFIG MESAGIHETT YNSIMKCDID IRKDLYANNV LSGGTTMYPG IADRMQKEIT ALAPSTMKIK IIAPPERKYS VWIGGSILAS LSTFQQMWIS KQEYDEAGPS IVHRKCF
靶标信息
Smooth Muscle Actin belongs to the actin family of proteins, which are highly conserved proteins that play a role in cell motility, structure and integrity. Alpha, beta and gamma actin isoforms have been identified, with alpha actin being a major constituent of the contractile apparatus, while beta and gamma actins are involved in the regulation of cell motility. In particular, smooth muscle actin is an alpha actin that is found in skeletal muscle. Actin exists as a ubiquitous protein involved with filament formation that make up large portions of the cytoskeleton. Actin filaments interact with myosin to assist in muscle contraction as well as aiding in cell motility and cytokinesis. Smooth muscle actin is found on smooth muscle vessel walls, gut wall, myometrium, myoepithelial cells in breast and salivary glands. Defects in the smooth muscle actin gene cause aortic aneurysm familial thoracic type 6. Actin isoforms differ slightly in their N-terminus and the sequences of each are perfectly conserved in higher vertebrates. Alpha-smooth muscle actin is abundant in vascular and visceral smooth muscle cells. In addition, it has also been shown that smooth muscle actin appear in stress fibers of fibroblastic cells during pathological situations involving contractile phenomena such as wound healing and fibrocontractive diseases. Multiple alternatively spliced variants of smooth muscle actin have been identified.
仅用于科研。不用于诊断过程。未经明确授权不得转售。
篇参考文献 (0)
生物信息学
蛋白别名: Actin Alpha 2 Smooth Muscle Aorta; Actin Vascular Smooth Muscle; Actin, aortic smooth muscle; Alpha Cardiac Actin; Alpha-actin-2; Aortic Smooth Muscle; asma; Cell growth-inhibiting gene 46 protein; Growth Inhibiting Gene 46; smooth muscle
基因别名: ACTA2; ACTSA; ACTVS; GIG46
Entrez Gene ID: (Human) 59